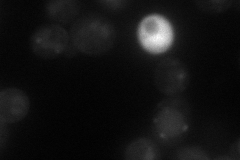
YKL217W
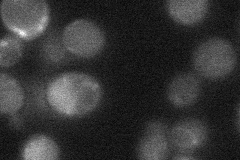
YKL217W

View description
Lactate transporter, required for uptake of lactate and pyruvate; phosphorylated; expression is derepressed by transcriptional activator Cat8p during respiratory growth, and repressed in the presence of glucose, fructose, and mannose
Localization:
Intensity:
Fold change:
Significance:
-
C’ GFP library in SD

below threshold18.06 -
N' NOP1pr-GFP in SD
cell periphery,vacuole32.3602 -
N' TEF2pr-mCherry in SD

vacuole48.8936 -
N' NATIVEpr-GFP in SD
below threshold21.4517 -
N' TEF2pr-VC and Cyto-VN in SD

below threshold24.711 -
C’ GFP library in SD+DTT

cytosol16.360.9No -
C’ GFP library in SD+H2O2

cytosol17.730.98No -
C’ GFP library in Starvation Media

cytosol14.590.8No -
C’ GFP library on the background of Pup2-DaMP

below threshold -
C’ GFP library on the background of CCT mutant

below threshold15.97970.884709No
